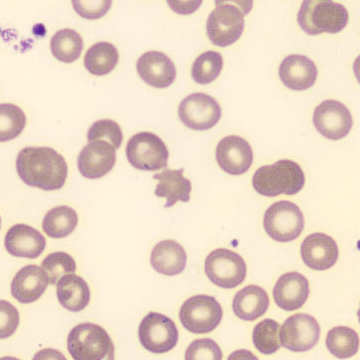
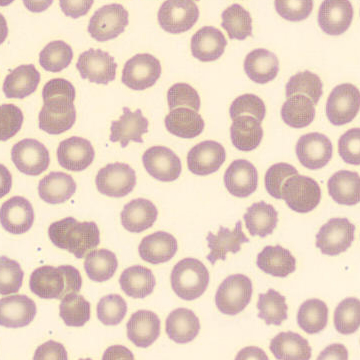
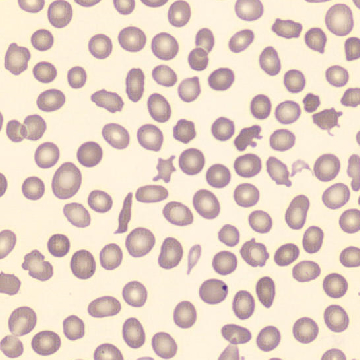
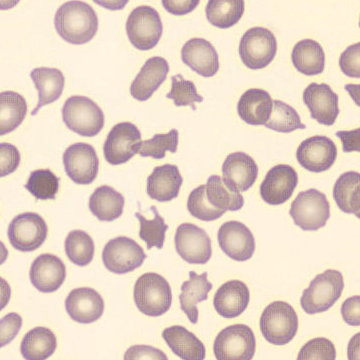
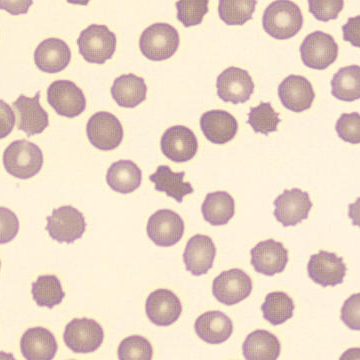
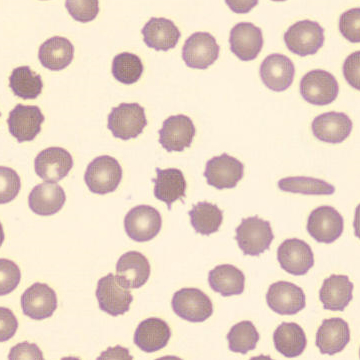
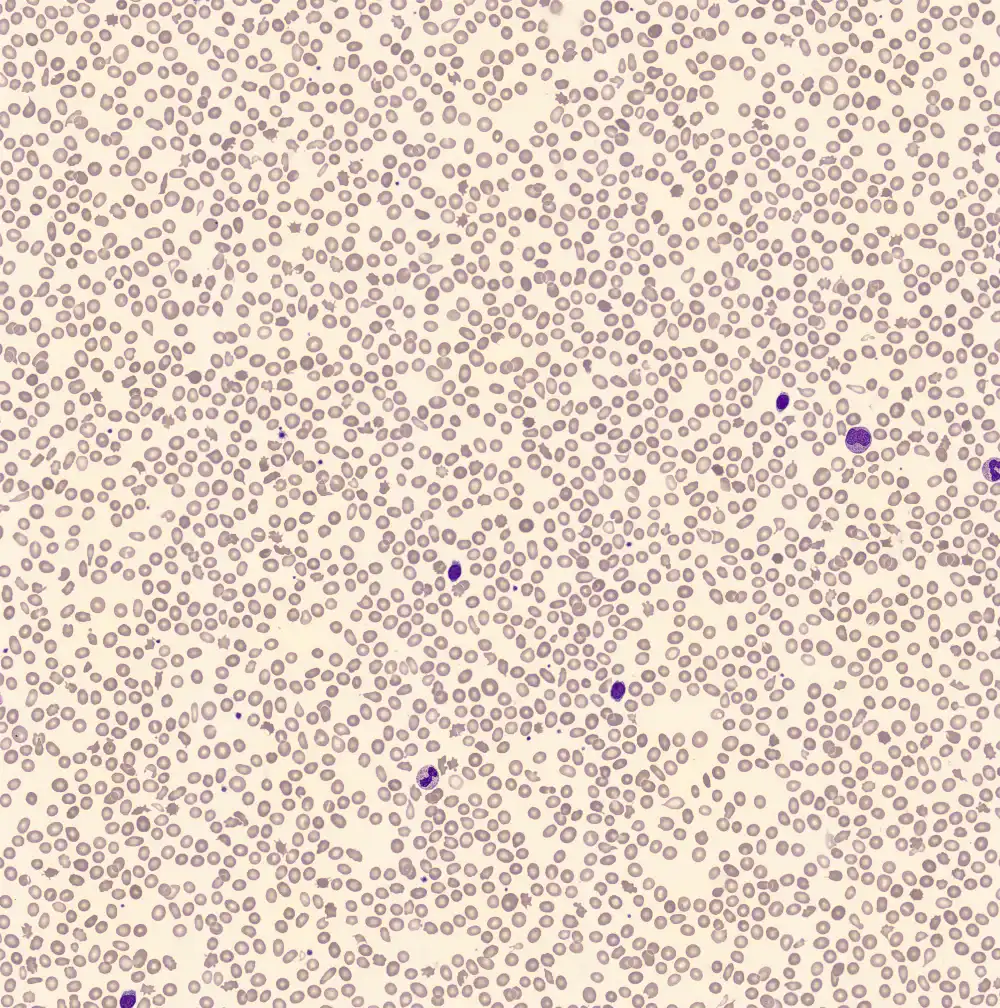

Doornappelcellen
Synoniemen: Echinocyten, Acanthocyten, Burr cells, Spurr cells, Crenocyten
Doornappelcellen zijn erytrocyten met meerdere uitsteeksels door verstoring van de celmembraan. Formeel wordt er onderscheid gemaakt tussen echinocyten (10-30 regelmatige uitsteeksels) en acanthocyten (<20 onregelmatige, puntige uitsteeksels), maar dit is in de praktijk vaak erg moeilijk. Hun etiologie is echter anders.
Acanthocyten ontstaan door een verhoogde opname van cholesterol in het membraan, wat gezien kan worden bij een verstoorde
lipide stofwisseling door bijvoorbeeld leverziekte. Echinocyten kunnen ontstaan bij het te langzaam drogen van een bloeduitstrijkje, langdurige blootstelling aan EDTA (artefact) of door een fysiologische verstoring van de osmotische gradiënt (en daarmee relatieve uitdroging van de erytrocyt).
Echinocyten




Acanthocyten

Echinocytose

Acanthocytose